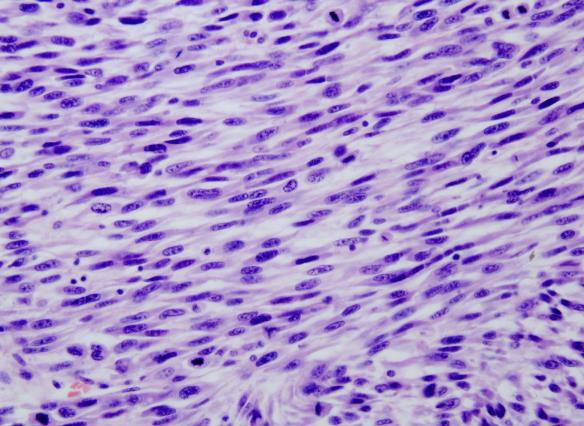
infographic

Wyszukaj egzamin lub pytanie
Egzamin PES Patomorfologia / jesień 2019
120 pytań
Pytanie 1
Jaki typ odczynu zapalnego występuje w biopsji mózgu z chorobą Creutzfeldta-Jakoba?
Pytanie 2
Hyperhomocysteinemia jest czynnikiem ryzyka: 1) choroby naczyń wieńcowych i obwodowych; 2) nieswoistego zapalenia jelita grubego; 3) udaru; 4) zakrzepicy żylnej; 5) zespołu złego wchłaniania. Prawidłowa odpowiedź to:
Pytanie 3
Wskaż prawdziwe stwierdzenia dotyczące gruczolakoraka in situ płuca (AIS - adenocarcinoma in situ): 1) w tomografii komputerowej klatki piersiowej charakteryzuje się zmianami o typie 'matowej szyby'; 2) rozpoznanie mikroskopowe nie jest możliwe na podstawie badania cytologicznego lub małych wycinków; 3) nie stwierdza się naciekania podścieliska, opłucnej, zatorów nowotworowych w naczyniach; 4) charakterystyczny jest typ tapetujący wzrostu i brak martwicy; 5) pojawienie się pojedynczego ogniska (≤ 5 mm) o utkaniu brodawkowatym lub drobnobrodawkowym nie wyklucza rozpoznania AIS. Prawidłowa odpowiedź to:
Pytanie 4
Zgodnie z zalecanym algorytmem postępowania u chorych z zaawansowa- nym niedrobnokomórkowym rakiem płuca, do badań molekularnych koniecznych do wdrożenia terapii inhibitorami kinazy tyrozynowej należy kwalifikować pacjentów z rozpoznaniem: 1) gruczolakorak; 2) rak pleomorficzny z komponentem gruczolakoraka; 3) rak niedrobnokomórkowy typu NOS; 4) rak gruczołowo-płaskonabłonkowy; 5) rak wielkokomórkowy neuroendokrynny. Prawidłowa odpowiedź to:
Pytanie 5
Wskaż prawdziwe stwierdzenie dotyczące rozetek Flexnera-Wintersteinera:
Pytanie 6
Mięsak jasnokomórkowy nerki:
Pytanie 7
W diagnostyce różnicowej guzów mezenchymalnych przewodu pokarmo- wego stwierdzenie rearanżacji genu ALK1 za pomocą fluorescencyjnej hybrydyzacji in situ (FISH) potwierdza rozpoznanie:
Pytanie 8
Które z wymienionych postaci histologicznych raków potrójnie ujemnych charakteryzują się korzystnym rokowaniem? 1) rak inwazyjny NST (invasive carcinoma of no special type); 2) rak gruczołowo-torbielowaty (adenoid cystic carcinoma); 3) rak wydzielniczy (secretory carcinoma); 4) rak metaplastyczny z komórek wrzecionowatych typu fibromatosis like (fibromatosis like metaplastic carcinoma); 5) rak z komórek obfitujących w tłuszcze (lipid rich cell carcinoma). Prawidłowa odpowiedź to:
Pytanie 9
W którym z poniższych przypadków nie występuje zwiększone ryzyko zachorowalności na raka sutka?
Pytanie 10
Chora lat 40 zgłosiła się na badanie mammograficzne, w rezultacie którego wykryty został 1,5 cm guzek w prawej piersi z widocznymi mikrozwapnie- niami. Obraz mikroskopowy wykazał dobrze odgraniczoną zmianę o utkaniu gruczołowym. Na przekroju nie stwierdzono ognisk martwicy. Budowa zrazikowa była zachowana, zraziki powiększone i zniekształcone. Wskaż rozpoznanie:
Pytanie 11
Badanie histopatologiczne wycinka skóry pobranego od pacjenta wykazu- je występowanie w warstwie siateczkowatej skóry wydłużonych, dendrytycznych melanocytów, które zawierają dużo gruboziarnistej melaniny. W obrazie widoczne są również liczne melanofagi. Komórki mają owalne jądra o obfitej, jasnej cytoplazmie zawierającej niewiele melaniny i układają się w wiązki. Której z poniższych zmian dotyczy ten opis?
Pytanie 12
W patomechanizmie której z poniższych chorób dziecięcych znaczną rolę odgrywa przyjmowanie kwasu acetylosalicylowego?
Pytanie 13
U pacjentki w wieku lat 44 rozpoznano okrągły guz w prawej nerce, w okolicy górnego bieguna, o średnicy 3 cm. Przeprowadzono operację, podczas której wycięto guz. Na przekroju był on koloru żółtego, z ogniskami białawymi i czerwonymi. W badaniu histopatologicznym jest zbudowany z okrągłych, czasem wielokątnych komórek o obfitej jasnej cytoplazmie i wyraźnych granicach. Której z poniższych chorób dotyczy powyższy opis?
Pytanie 14
Nasieniak spermatocytowy: 1) nie wchodzi w skład guzów germinalnych histologicznie niejednorodnych; 2) nie ma związku z wnętrostwem; 3) wywodzi się z wewnątrzkanalikowej neoplazji komórek rozrodczych (IGCN); 4) zbudowany jest z komórek zawierających glikogen; 5) jest nowotworem wybitnie promienioczułym. Prawidłowa odpowiedź to:
Pytanie 15
Wskaż fałszywe stwierdzenie dotyczące nowotworu pęcherzyka żółtkowego (yolk sac tumor):
Pytanie 16
Zespół paraneoplazmatyczny w postaci hiperkalcemii występuje w niżej wymienionych nowotworach, z wyjątkiem:
Pytanie 17
Nowotwór podścieliskowy żołądka wywodzi się z:
Pytanie 18
Badanie histopatologiczne wycinka pobranego z grzbietowej części prącia wykazało zmianę brodawkowatą z wakuolizacją komórek nabłonkowych w warstwie powierzchownej oraz naciekaniem miejscowym przez zmianę, inaczej zwaną guzem Buschke-Lowenstaina. Najbardziej prawdopodobne rozpoznanie to:
Pytanie 19
Najczęstszą przyczyną niewydolności kory nadnerczy jest/są:
Pytanie 20
46-letnia chora z wywiadem wycieku wydzieliny z brodawki od 4-miesięcy. Wycinki z biopsji wykazały obecność komórek olbrzymich z jasną cytoplazmą. Komórki lokalizowały się w naskórku i wykazywały ekspresję PAS-dodatnią, cytokeratyny lekkie. Wskaż prawidłową diagnozę:
Pytanie 21
W skład utkania guzów germinalnych jądra histologicznie niejednorodnych (mieszanych) nie wchodzi:
Pytanie 22
W przypadku rodzinnego raka piersi zależnego od mutacji BRCA2 najczęstszym typem molekularnym jest typ:
Pytanie 23
Chora lat 45 zgłosiła się do ginekologa z guzkiem na sromie wielkości 1 cm. Obraz mikroskopowy wykazał zmianę dobrze odgraniczoną, zbudowaną z brodawkowatych rozrostów nabłonka jedno- lub dwuwarstwowego, z widoczną warstwą komórek mioepitelialnych. Najbardziej prawdopodobne rozpoznanie w związku z lokalizacją zmiany to:
Pytanie 24
Cechą charakterystyczną nabłoniaka kosmówkowego związanego z ciążą nie jest:
Pytanie 25
Właściwość określana mianem tzw. 'asymetrycznej replikacji' jest charakterystyczna dla:
Pytanie 26
Które z poniższych markerów są przydatne w różnicowaniu międzybłoniaka opłucnej i odczynowego rozrostu międzybłonka: 1) CK5/6; 2) kalretynina; 3) EMA; 4) desmina; 5) P53. Prawidłowa odpowiedź to:
Pytanie 27
Powikłaniami zespołu zaburzeń oddychania noworodków są niżej wymienione, z wyjątkiem:
Pytanie 28
Najistotniejsze skutki działania wolnych rodników to: 1) agregacja nieprawidłowo zwiniętych białek; 2) utlenianie białek; 3) uszkodzenie DNA; 4) utlenianie lipidów błon komórkowych; 5) aktywacja dopełniacza. Prawidłowa odpowiedź to:
Pytanie 29
Do czynników hamujących angiogenezę zalicza się:
Pytanie 30
Główne morfologiczne cechy odwracalnego uszkodzenia komórek widoczne w mikroskopie świetlnym to: 1) przekrwienie; 2) obrzmienie miąższowe; 3) zwyrodnienie wodniczkowe; 4) stłuszczenie; 5) martwica rozpływna. Prawidłowa odpowiedź to:
Pytanie 31
Wskaż białko o działaniu antyapoptotycznym:
Pytanie 32
Szczególne cechy zakażenia gruźliczego w AIDS to: 1) najczęstsza lokalizacja w górnym płacie płuca; 2) częsta gruźlica prosowata; 3) częsta gruźlica pozapłucna; 4) częsta gruźlica jamista; 5) częste szczepy lekooporne. Prawidłowa odpowiedź to:
Pytanie 33
Wrzód twardy Huntera jest typową zmianą w:
Pytanie 34
Chlamydiozy to choroby zakaźne występujące najczęściej w: 1) śliniankach; 2) narządach układu moczowo-płciowego; 3) gałce ocznej; 4) płucach; 5) skórze. Prawidłowa odpowiedź to:
Pytanie 35
Komórki Warthina-Finkeldeya są patognomoniczną cechą obrazu mikroskopowego:
Pytanie 36
Najczęstszym powikłaniem nagminnego zapalenia ślinianek przyusznych jest zapalenie:
Pytanie 37
Najczęstszymi nowotworami łagodnymi u dzieci są:
Pytanie 38
Wskaż triadę zmian w płucach typową dla zespołu zaburzeń oddychania noworodków: 1) naciek zapalny z plazmacytów; 2) przekrwienie; 3) niedodma; 4) błony szkliste; 5) niedokrwienie. Prawidłowa odpowiedź to:
Pytanie 39
Chłoniak rozlany z dużych komórek B: 1) charakteryzuje się agresywnym przebiegiem; 2) jest nowotworem osób starszych; 3) pozawęzłowo najczęściej lokalizuje się w śledzionie; 4) często zajmuje szpik kostny i krew obwodową; 5) jest jednym z najczęstszych chłoniaków nieziarniczych. Prawidłowa odpowiedź to:
Pytanie 40
Miażdżyca najczęściej dotyczy: 1) tętnic kończyn dolnych; 2) tętnic szyjnych; 3) tętnic wieńcowych serca; 4) tętnic krezkowych; 5) tętnic nerkowych. Prawidłowa odpowiedź to:
Pytanie 41
Chłoniak zbudowany z mieszaniny centrocytów i centroblastów, zazwyczaj z dominującą strukturą grudkową, to:
Pytanie 42
Ziarniniakowe zapalenie węzłów chłonnych z tworzeniem ropni jest typowe dla:
Pytanie 43
Kalcytonina jest biomarkerem:
Pytanie 44
Guz ziarnistokomórkowy jest nowotworem łagodnym:
Pytanie 45
Markerami komórek śródbłonka, przydatnymi w immunohistochemicznej diagnostyce różnicowej nowotworów, są: 1) białko S-100; 2) CD31; 3) EMA; 4) CD34; 5) F VIII. Prawidłowa odpowiedź to:
Pytanie 46
Niedobór kwasu foliowego u kobiet w ciąży zwiększa ryzyko wrodzonych:
Pytanie 47
Typową cechą chłoniaka anaplastycznego z dużych komórek, ALK- dodatniego (ALCL, ALK+) jest:
Pytanie 48
Typowy immunofenotyp chłoniaka Burkitta (BL) obejmuje niżej wymienione antygeny, z wyjątkiem:
Pytanie 49
Mięsak Ewinga i niedojrzały guz neuroektodermalny (PNET) różnią się:
Pytanie 50
Który z niżej wymienionych nowotworów ma związek przyczynowy z wirusem HTLV-1?
Pytanie 51
Wskaż fałszywe stwierdzenie dotyczące choroby hemolitycznej noworodków:
Pytanie 52
Który z niżej wymienionych guzów należy do kategorii nowotworów o pośredniej złośliwości, rzadko przerzutujących?
Pytanie 53
Wskaż prawdziwe stwierdzenie dotyczące nowotworów serca:
Pytanie 54
Wskaż nowotwór, w którym typowo stwierdza się splenomegalię, pancytopenię i tzw. suchą punkcję szpiku:
Pytanie 55
Wskaż nowotwory, w których występuje mutacja genu JAK2: 1) nadpłytkowość samoistna; 2) przewlekła białaczka eozynofilowa; 3) mastocytoza systemowa; 4) czerwienica prawdziwa; 5) pierwotna mielofibroza. Prawidłowa odpowiedź to:
Pytanie 56
W diagnostyce różnicowej między przewlekłą białaczką limfocytarną / chłoniakiem limfocytarnym z małych limfocytów (B-CLL/SLL) i chłoniakiem z komórek płaszcza (MCL) istotne znaczenie ma odczyn immunohistochemiczny na obecność:
Pytanie 57
Które z niżej wymienionych nowotworów wykazują typowo ekspresję antygenu CD34? 1) odosobniony guz włóknisty; 2) guz olbrzymiokomórkowy pochewki ścięgna; 3) włókniakomięsak guzowaty skóry; 4) śródbłoniak nabłonkowaty; 5) mięsak Ewinga. Prawidłowa odpowiedź to:
Pytanie 58
Wskaż fałszywe stwierdzenie dotyczące mięsaka Kaposiego:
Pytanie 59
Wszystkie niżej wymienione można określić jako rozrost patologiczny, z wyjątkiem:
Pytanie 60
Niezbędne do postawienia diagnozy choroby Hirschsprunga jest stwierdzenie w preparacie histopatologicznym:
Pytanie 61
W rutynowym badaniu krwi u 60-letniej pacjentki z zapaleniem tarczycy wykryto objawy niedokrwistości złośliwej. W preparacie histopatologicznym z dna żołądka widoczne jest rozlane uszkodzenie komórek okładzinowych błony śluzo- wej oraz jej ścieńczenie i utrata fałdowania. W kilku miejscach widoczna jest również metaplazja jelitowa. Które z poniższych chorób należy zdiagnozować?
Pytanie 62
Pobrano materiał do badania histopatologicznego z jądra 25-letniego mężczyzny. Guz był słabo odgraniczony, z ogniskami martwicy i wylewów krwi. W obrazie mikroskopowym obserwuje się duże komórki o zasadochłonnej cytoplazmie, niewyraźnych granicach oraz dużych jądrach z wyraźnymi jąderkami. Komórki leżą w litych polach bez cech zróżnicowania. Który z poniższych nowotworów jąder odpowiada podanemu opisowi?
Pytanie 63
Do diagnostyki pobrano od pacjenta guz przynasady dalszej kości udowej. Makroskopowo był on szaro-białawy o piaskowym wyglądzie, ze zamianami krwotocznymi oraz torbielowatymi. Mikroskopowo stwierdza się komórki z dużymi hiperchromatycznymi jądrami różniące się między sobą kształtem i wytwarzające osteoid. Powyższy opis odpowiada:
Pytanie 64
Wskaż prawdziwe stwierdzenia dotyczące nowotworów kości: 1) najczęstszą postacią złośliwych guzów kości są nowotwory przerzutowe; 2) wyrośla chrzęstno-kostne mogą być dziedziczone; 3) spośród nowotworów przerzutowych gruczolakorak stercza powoduje zmiany osteolityczne; 4) mięsak Ewinga rośnie w jamie szpikowej najczęściej trzonów lub przynasad kości; 5) guz olbrzymiokomórkowy powoduje zmiany lityczne niszczące korę najczęściej nasad kości długich. Prawidłowa odpowiedź to:
Pytanie 65
Podczas sekcji mózgu stwierdza się ogniska krwotoków i martwicy, szczególnie w ciałach suteczkowatych podwzgórza oraz w okolicach komór, trzeciej i czwartej. W preparacie pomimo obecności martwicy neurony są względnie dobrze zachowane. Widoczne są torbielowate przestrzenie z makrofagami obładowanymi żelazem. Które z poniższych rozpoznań najlepiej pasuje do powyższego opisu?
Pytanie 66
Sekcja zwłok pacjenta wykazała znacznie rozdęte płuca z niewielkimi polami niedodmy. Oskrzeliki były zaczopowane przez śluzową wydzielinę. Ściany dróg oddechowych pogrubiałe. W obrazie histologicznym widoczne były między innymi czopy zawierające złuszczone kępki komórek nabłonkowych, liczne eozynofile oraz kryształy Charcota-Leydena. Wskaż rozpoznanie:
Pytanie 67
Opis: Histologicznie guz jest zbudowany z mieszaniny komórek nabłonkowatych, komórek olbrzymich wielojądrowych oraz piankowatych histiocytów i hemosyderynofagów. Jednojądrowe komórki nabłonkowate (zasadniczy składnik nowotworowy) charakteryzują się dużym okrągłym jądrem (czasem z obecnością bruzd), wyraźnym pojedynczym jąderkiem i umiarkowaną ilością cytoplazmy. Zwraca uwagę obecność dość licznych figur podziału mitotycznego, przy czym nie obserwuje się figur patologicznych (...) najprawdopodobniej odpowiada:
Pytanie 68
78-letnia pacjentka została przyjęta na oddział okulistyki z powodu nagłej utraty wzroku. W wywiadzie ujawniła wcześniejsze osłabienie, gorączkę, uczucie zmęczenia oraz miejscowy ból głowy w okolicy skroniowej pojawiający się przy palpacji w tym miejscu. W materiale pobranym w biopsji widać grudkowe pogrubienie błony wewnętrznej, cechy ziarniniakowego zapalenia w obrębie warstwy wewnętrznej błony środkowej, naciek z limfocytów i makrofagów oraz fragmentacje błony sprężystej wewnętrznej. Opis odpowiada:
Pytanie 69
Który z wymienionych niżej nowotworów cechuje się niewielkim polimorfizmem komórek, niewielką aktywnością mitotyczną i łagodnym przebiegiem klinicznym?
Pytanie 70
Wycinki tkankowe barwione hematoksyliną i eozyną (małe i średnie powiększenie) pochodzą z pierwotnego guza zlokalizowanego w przestrzeni zaotrzewnowej u chorej w średnim wieku. Na postawie mikroskopowego obrazu utkania guza można podejrzewać, że komórki nowotworu cechują się ekspresją:
Pytanie 71
Nerki 65-letniego pacjenta wykazują symetryczny zanik. W obrazie mikroskopowym obserwuje się w preparatach z obu nerek pogrubienie i szkliwienie ścian tętniczek, masy szkliste powodują zwężenie światła naczyniowego i zatarcie struktury komórkowej. Obraz najprawdopodobniej odpowiada:
Pytanie 72
Wskaż czynnik powodujący zapalenie wątroby na tle zastoju żółci:
Pytanie 73
Które cechy kliniczno-morfologiczne atypowego guza włóknisto- ksantomatycznego (atypical fibroxanthoma) pozwalają za zróżnicowanie tego guza z mięsakiem pleomorficznym?
Pytanie 74
Przedstawione na rycinie utkanie mikroskopowe (rycina strona lewa) i wynik badania immunohistochemicznego na obecność białkowego produktu genu SMARCB1/INI-1 (rycina strona prawa) odpowiadają:

Pytanie 75
Wskaż prawdziwe stwierdzenie dotyczące komórek o typie lipoblasta:
Pytanie 76
Do rozrostów z komórek mezenchymalnych, które w głównej mierze umiejscowione są w tkance podskórnej należą:
Pytanie 77
Do czynników ryzyka raka endometrioidalnego trzonu macicy, nie zalicza się:
Pytanie 78
Tzw. drżenie trzepoczące jest objawem towarzyszącym:
Pytanie 79
Wirus Norwalk (norovirus) wywołuje:
Pytanie 80
Masywne powiększenie śledziony (masa powyżej 1000 g) obserwuje się w przebiegu:
Pytanie 81
Zaburzenia funkcji genu CFTR (regulator transportu przez błonę komórkową) są obserwowane w:
Pytanie 82
Ropnie gwiazdkowate obserwuje się w:
Pytanie 83
Arytmogenna kardiomiopatia prawokomorowa:
Pytanie 84
Wszystkie niżej wymienione należą do obrazu zespołu CREST, z wyjątkiem:
Pytanie 85
Chorobą związaną z IgG4 jest:
Pytanie 86
Stosowanie doustnych środków antykoncepcyjnych przez długi czas może spowodować powstanie:
Pytanie 87
Do najczęstszych chorób płuc związanych z paleniem tytoniu należą: 1) niedodma; 2) rozedma; 3) ostre zapalenie oskrzeli; 4) rak płuca; 5) przewlekłe zapalenie oskrzeli. Prawidłowa odpowiedź to:
Pytanie 88
Nacieki zapalne złożone z komórek jednojądrowych są typowe dla zakażeń:
Pytanie 89
Wskaż trzy nowotwory, w których stwierdza się nabytą mutację kinazy seryno/treoninowej BRAF: 1) rak płaskonabłonkowy płuca; 2) czerniak skóry; 3) białaczka włochatokomórkowa; 4) rak pęcherzykowy tarczycy; 5) nowotwór podścieliskowy przewodu pokarmowego (GIST). Prawidłowa odpowiedź to:
Pytanie 90
Atypowe zapalenie płuc jest najczęściej spowodowane przez:
Pytanie 91
W badaniu mikroskopowym wycinków z płuc pobranych podczas autopsji stwierdzono pogrubienie przegród z niewielkim naciekiem zapalnym z komórek jednojądrowych oraz piankowaty wysięk typu 'waty cukrowej' w świetle pęcherzyków. Obraz mikroskopowy sugeruje zakażenie:
Pytanie 92
Szybko postępujące kłębuszkowe zapalenie nerek z półksiężycami może być spowodowane: 1) odkładaniem kompleksów immunologicznych; 2) odkładaniem przeciwciał skierowanych przeciwko kłębuszkowej błonie podstawnej; 3) obecnością przeciwciał skierowanych przeciwko cytoplazmie neutrofilów (ANCA); 4) pierwotnym uszkodzeniem podocytów; 5) mutacją genów kodujących białka kłębuszkowej błony podstawnej. Prawidłowa odpowiedź to:
Pytanie 93
Beta2-mikroglobulina jest białkiem prekursorowym w skrobiawicy:
Pytanie 94
Ogniskowe i segmentalne stwardnienie kłębuszków nerkowych spowodowane jest:
Pytanie 95
Dominujący obraz przerostu grudek chłonnych w zmianach zapalnych węzłów chłonnych jest typowy dla: 1) toksoplazmozy; 2) mononukleozy zakaźnej; 3) zapalenia gośćcowego; 4) reakcji polekowych; 5) wczesnego okresu infekcji HIV. Prawidłowa odpowiedź to:
Pytanie 96
Najczęstszym złośliwym, pierwotnym nowotworem gruczołów ślinowych, zwykle związanym z rearanżacją chromosomową dotyczącą genu MAML2 jest:
Pytanie 97
Do czynników ryzyka raka płaskonabłonkowego jamy ustnej należą: 1) nadużywanie alkoholu; 2) zakażenie wirusem HPV; 3) zakażenie wirusem EBV; 4) palenie tytoniu; 5) zakażenie Candida albicans. Prawidłowa odpowiedź to:
Pytanie 98
Zespół Wernickego-Korsakowa jest najczęściej spowodowany:
Pytanie 99
Fagocytoza martwych kardiomiocytów oraz formowanie ziarniny zapalnej na obwodzie zmian martwiczych w ognisku zawału mięśnia serca stwierdza się w:
Pytanie 100
Kserostomia może być spowodowana: 1) radioterapią; 2) autoimmunologicznym zapaleniem ślinianki w zespole Sjögrena; 3) terapią lekami przeciwdepresyjnymi; 4) torbielą śluzową gruczołu ślinowego; 5) zakażeniem promieniowcem. Prawidłowa odpowiedź to:
Pytanie 101
Do pozajelitowych chorób towarzyszących chorobie Crohna zalicza się: 1) zapalenie błony naczyniowej oka; 2) rumień guzowaty; 3) torbielowatość nerek; 4) wędrujące zapalenie stawów; 5) malformacje naczyń mózgu. Prawidłowa odpowiedź to:
Pytanie 102
Lity, zazwyczaj jednostronny nowotwór jajnika zbudowany z obfitego zrębu zawierającego gniazda nabłonka typu przejściowego to:
Pytanie 103
Wskaż fałszywe stwierdzenie dotyczące rogowacenia łojotokowego:
Pytanie 104
Spośród wymienionych mutacji, w proliferacjach melanocytarnych najczęściej stwierdza się:
Pytanie 105
Do najczęstszych nieurazowych krwotoków podpajęczynówkowych należy pęknięcie tętniaka workowatego. Wykonując sekcję pacjenta, który zginął z takiego powodu, można przypuszczać, że tętniak najprawdopodobniej jest zlokalizowany w tętnicy:
Pytanie 106
W trakcie sekcji zwłok pacjenta z rozsianą chorobą nowotworową zauważono na zastawkach serca małe, ok. 2-4 mm średnicy, wyrośla. W badaniu mikroskopowym stwierdzono, że odpowiadają one złogom włóknika. Przedstawiony opis najbardziej odpowiada:
Pytanie 107
64-letni pacjent leczony z powodu chłoniaka oraz ze zdiagnozowanymi wcześniej cechami niewydolności nerek, uskarża się w ostatnich miesiącach na bóle stawowe; po wielu wizytach u ortopedy ostatecznie zdecydowano się na pobranie wycinka maziówki, w której stwierdzono obecność guzków. W odniesieniu do przedstawionego opisu, w badaniu mikroskopowym należy spodziewać się:
Pytanie 108
Wskaż fałszywe stwierdzenie dotyczące pheochromocytoma:
Pytanie 109
W trakcie sekcji 76-letniego pacjenta z długotrwającą cukrzycą do badania pobrano m.in. nerki. Która z niżej wymienionych zmian mikroskopowych w materiale z nerek jest patognomoniczna dla cukrzycy?
Pytanie 110
Obecność koncentrycznych zwapniałych struktur w nowotworze tarczycy jest najbardziej charakterystyczna dla raka:
Pytanie 111
U 42-letniej pacjentki podejrzewano rozwój zaśniadu. Pobrano materiał do badania histopatologicznego. W celu różnicowania obecności zaśniadu całkowitego i częściowego najlepiej wykonać:
Pytanie 112
Przebudowa miąższu wątroby związana z martwicą, zapaleniem, włóknieniem i powstawaniem zrazików pozbawionych żyły centralnej oraz narastającymi wykładnikami przewlekłej niewydolności (klinicznie i laboratoryjnie), jest najmniej prawdopodobna po zakażeniu wywołanym:
Pytanie 113
Wśród wymienionych najczęstszym nowotworem wyrostka robaczkowego jest:
Pytanie 114
W typowym dla wieku dziecięcego nowotworze, oprócz typowego obrazu mikroskopowego tzw. małych okrągłych komórek (ang. SBCT), stwierdza się także zadziwiająco dobre rokowanie w przypadku choroby w czwartym stadium zaawansowania, opisywanym jako 'stage IVs'. Typowe zaburzenie genetyczne stwierdzane w opisanym nowotworze dotyczy genu:
Pytanie 115
Obecność w żołądku mnogich polipów o owalnym kształcie, średnicy poniżej 1 cm i z gładką powierzchnią, które w badaniu mikroskopowym opisywane są jako nieregularnie poszerzone i wydłużone gruczoły dołeczkowe żołądka, czasem z niewielkimi nadżerkami na powierzchni zmiany, a w obrzękniętej blaszce właściwej obecny jest naciek zapalny - najbardziej odpowiada zmianom u pacjenta w wieku:
Pytanie 116
Wskaż najbardziej typową zmianę morfologiczną stwierdzaną w płucach w przebiegu wstrząsu:
Pytanie 117
Która choroba występuje głównie rodzinnie i jest związana z zaburzeniem budowy białka, którego duże ilości znajdują się w ścianie aorty, więzadłach (w tym także utrzymujących na właściwym miejscu soczewkę oka) oraz zaburzeniami w obrębie genu FBN1?
Pytanie 118
Z występowaniem wapnienia przerzutowego mamy do czynienia w niżej wymienionych sytuacjach, z wyjątkiem:
Pytanie 119
U 24-letniego mężczyzny, u którego rozpoznano wrodzone zaburzenie polegające na upośledzeniu transportu jonów chloru (głównie w komórkach nabłonkowych), stwierdzono typowe cechy choroby związane z ww. nieprawidłowością, takie jak: przebyte smółkowe zapalenie jelita grubego oraz nawracające zapalenia płuc wywołane Pseudomonas aeruginosa. Należy spodziewać się także innych następstw tej choroby, z wyjątkiem:
Pytanie 120